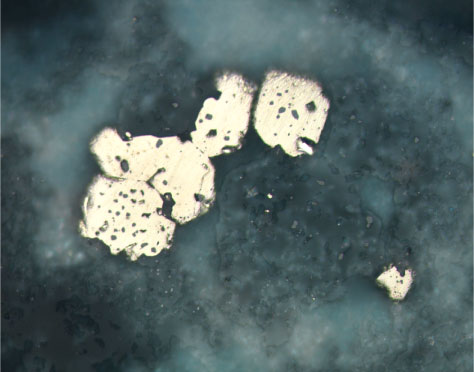

Figure F91. Tiny magnetite (gray) inclusions in pyrite (white). Groundmass contains magnetite grains within quartz that are the same size and shape as the magnetite inclusions in the pyrite (Sample 193-1188F-13Z-1 [Piece 3B, 47-50 cm] in reflected light; width of view = 0.275 mm. Photomicrograph ID# 1188F_62; thin section 77).
![]()